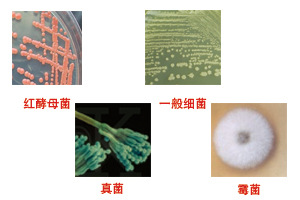
MS0101-002

相关产品推荐更多 >
万千商家帮你免费找货
0 人在求购买到急需产品
- 详细信息
- 询价记录
- 技术资料
- 供应商:
友康
- 规格:
81支/盒
| 一、菌种保存管 产品用途 | ||||||||||||||||||||||||||||||||||||||||||||||||||||||
| 菌种保存管是实验室保存菌种的容器,菌种保存管内有25颗表面凹孔小瓷珠用于细菌的吸附和保存,可在保存周期内使用25次(每次1个)。菌种保存管使用过程中,将细菌接种在菌种保存管内,放置于-20℃或-80℃环境中可长期保存(视不同菌种与保存温度,一般可保存3-10年),同时菌种保存管的取用和保存较为便利(取用复苏及保存菌株仅需1分钟)。 |
||||||||||||||||||||||||||||||||||||||||||||||||||||||
| 二、菌种保存管 产品规格 | ||||||||||||||||||||||||||||||||||||||||||||||||||||||
|
||||||||||||||||||||||||||||||||||||||||||||||||||||||
| 三、菌种保存管 产品性能 | ||||||||||||||||||||||||||||||||||||||||||||||||||||||
| 1、日本进口多孔磁珠,负载率高 | ||||||||||||||||||||||||||||||||||||||||||||||||||||||
|
||||||||||||||||||||||||||||||||||||||||||||||||||||||
| 2、使用范围广 | ||||||||||||||||||||||||||||||||||||||||||||||||||||||
|
||||||||||||||||||||||||||||||||||||||||||||||||||||||
|
||||||||||||||||||||||||||||||||||||||||||||||||||||||
| 四、菌种保存管 不同之处 | ||||||||||||||||||||||||||||||||||||||||||||||||||||||
| 1、 更严格的质量控制 | ||||||||||||||||||||||||||||||||||||||||||||||||||||||
|
||||||||||||||||||||||||||||||||||||||||||||||||||||||
| 2、 我们的试剂 | ||||||||||||||||||||||||||||||||||||||||||||||||||||||
|
||||||||||||||||||||||||||||||||||||||||||||||||||||||
| 3.不同菌种保存方法的对比 | ||||||||||||||||||||||||||||||||||||||||||||||||||||||
|
||||||||||||||||||||||||||||||||||||||||||||||||||||||
| 五、菌种保存管 使用方法 | ||||||||||||||||||||||||||||||||||||||||||||||||||||||
| 菌种保存方法 | ||||||||||||||||||||||||||||||||||||||||||||||||||||||
|
||||||||||||||||||||||||||||||||||||||||||||||||||||||
| 菌种复苏方法 | ||||||||||||||||||||||||||||||||||||||||||||||||||||||
|
||||||||||||||||||||||||||||||||||||||||||||||||||||||
风险提示:丁香通仅作为第三方平台,为商家信息发布提供平台空间。用户咨询产品时请注意保护个人信息及财产安全,合理判断,谨慎选购商品,商家和用户对交易行为负责。对于医疗器械类产品,请先查证核实企业经营资质和医疗器械产品注册证情况。
- 作者
- 内容
- 询问日期
技术资料暂无技术资料 索取技术资料
友康 MS0101 瓷珠法菌株保存用 菌种保存管(81支/盒)
¥980